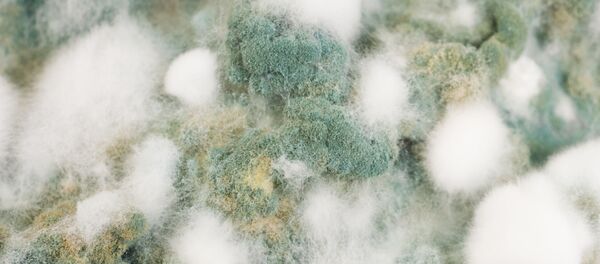
Плесень, архивное фото.  - Sputnik Молдова

Сегодня стирка белья - вопрос плевый. Купил порошок, засыпал в соответствующий отсек, нажал на кнопку и - "вуаля".
Чего только раньше не делали женщины, чтобы все члены семьи выглядели опрятно. Стирали на мостках в озере или в реке, "жамкали" белье вручную в тазике, усердно терли о ребристую доску, "подсиняли".
Сегодня необходимость так ударно "вкалывать" у современных женщин отпала, по крайней мере в плане стирки белья. Машины-автоматы давно избавили домохозяек от утомительных и ненужных хлопот: достаточно выбрать правильную программу стирки для определенного типа вещей или белья и, как говорится, вопрос решен.
Но и стиральная машина может подвести свою владелицу в случае, если за ней неправильно ухаживать, ведь техника, как известно, тоже любит внимание. Самый страшный приговор "стиралке" — это не накипь, которой пугают маркетологи в телевизионной рекламе, призывая покупать для борьбы с ней дорогие чистящие средства.
Враг, которого не ждали
Оказывается, со временем в стиральной машине начинают жить различные виды плесневых грибков, которые несут прямую угрозу здоровью всех домочадцев и животных, живущих в квартире.
О том, что резиновый обод барабана стиральной машины периодически надо протирать от скапливающейся грязи, знают все. Но этого недостаточно, и проблему удаления неприятного запаха это ни в коей мере не решит.
Оказывается, что в режиме тридцатиградусной "быстрой стирки", который, экономя время, используют тысячи домохозяек в нашей стране, внутри стиральной машины начинают появляться и разрастаться в геометрической прогрессии плесневые грибки, которые весьма вольготно себя чувствуют при таких температурах и в буквальном смысле опутывают машину-автомат своими колониями. А вот "выселить" их оттуда — задача весьма затейливая.
Как "выжить" плесень
В целях профилактики равно, как и тогда, когда грибки оккупировали внутренности стиральной машины, хозяйкам следует иметь на вооружении следующую простую схему тотальной победы над плесенью.
Первое, что необходимо, обработать барабан и его каучуковый обод чистящим средством с хлором. Естественно эту процедуру надо производить в плотных резиновых перчатках. После того, как внутреннее пространство стиральной машины обработано, надо закрыть ее дверцу на два часа, чтобы хлор мог "атаковать".
Далее необходимо включить машину-автомат и запустить режим полоскания, чтобы химический раствор был полностью удален. Но "контрольным выстрелом" по плесени станет лимонная кислота. Ее необходимо засыпать в отсек для порошка и запустить стирку в режиме температурного максимума. Обычно это — 90 градусов Цельсия.
Опасность для здоровья человека
Наибольшую опасность для здоровья человека представляют споры плесени. Так, к примеру, попадая на ногти и волосы, они могут вызвать их поражение. Оказываясь на кожном покрове, споры грибков приводят к экземе и дерматиту, различным высыпаниям непонятной, на первый взгляд, для врачей этиологии. Более того, необъяснимые приступы острой головной боли также могут вызваны спорами грибков.
Помимо этого, споры плесени способны вызывать и приступы аллергии, в результате чего человека может мучить сильный насморк, приступы удушья и кашля, воспаление слизистых оболочек глаз. Более того, регулярное вдыхание споров грибков способно привести к развитию такого хронического заболевания, как бронхиальная астма.
Будь в курсе всех новостей в Молдове и мире! Подпишись на наш канал в Telegram>>>